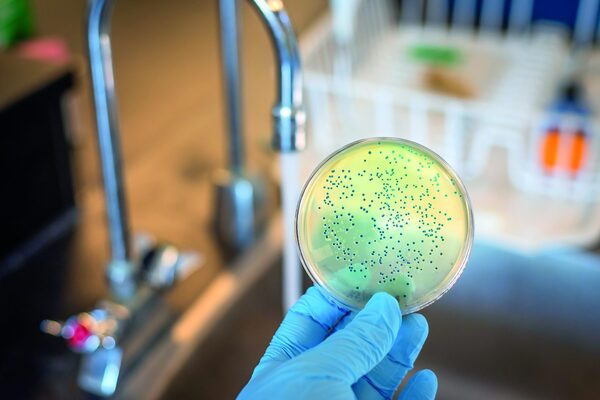

bacterias ndm
ndm-cre
ee. uu
oms
delhi
danielle rankinla
cdc
annals
internal medicine
laboratorios
antimicrobianos
cre
históricamente
klebsiella
kpc
ndm
recomendaciones
coordinarse
implementar
india
suecia
asia meridional
África
latina
enfermedades
verificar
Moopio.com no es responsable por las acciones de los sitios web de terceros ni por el contenido que estos publiquen. Las noticias y artículos a los que se enlaza desde este sitio son propiedad y responsabilidad de los autores y editores originales. No tenemos control sobre la veracidad, precisión, o legalidad de la información contenida en estos sitios. Más informacion en Términos de Servicio.
Compartir en Facebook Compartir en Twitter Compartir en Whatsapp Noticias Populares Últimas Noticias